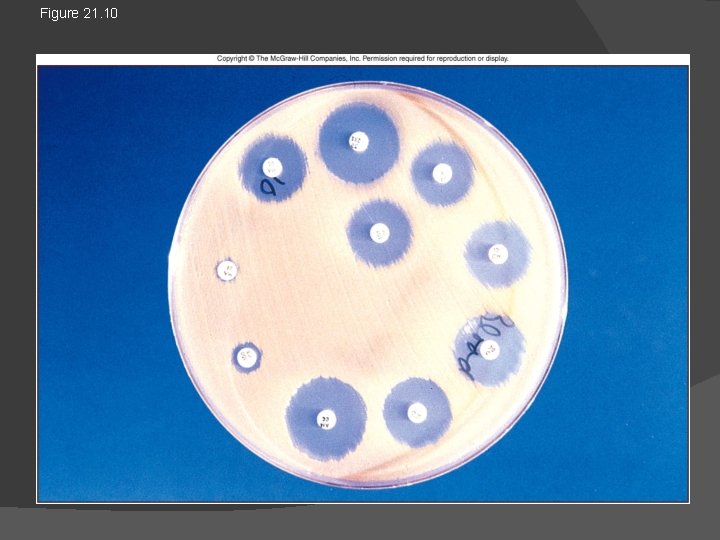
Figure 21. 10

Antibiotics Susceptibility testing Antibiotics Susceptibility testing Antibiotics susceptibility

Antibiotics Susceptibility testing

Antibiotics Susceptibility testing: - Antibiotics susceptibility testing of the isolated pathogen can indicate specifically which drug are most effective in suppressing or destroying it. - Antibiotics susceptibility testing can give a great assistance the physician in selecting effective antibiotics drugs for specific chemotherapy of infections disease.

- The method of testing most frequently used is the standardized paper disk agar diffusion method, also known as the Kirby-Bauer method. - A number of small sterile filter disk of uniform size that have each been impregnated with an antibiotic in defined concentration are placed on the surface of an agar plate previously seeded with a standard amount of the organism to be tested.

- When the disks are in firm contact with the agar, their antibiotics diffuse into the surrounding medium and there come in contact with the multiplying organisms. The plates are incubated at 35 oc for 18 -24 hours. - After incubation, the plates are examined for the presence of zones of inhibition of bacterial growth (clear rings) around the antibacterial disks. If there is no inhibition, the organism is reported as resistant (R) to the antibiotic in the disks. If there is inhibit a zone of inhibition surrounding the antibiotic disk, the organism is not susceptible (s) to the drug being tested.

Diffusion methods Kirby-Bauer method or disk diffusion antibiotic sensitivity testing: Small filter paper disks containing antibiotics are placed onto a plate upon which bacteria are growing. The antibiotic diffuses from the disk into the agar. If the bacteria are sensitive to the antibiotic, a clear ring, or zone of inhibition, is seen around the disk indicating poor growth. Using special comparators that interpret the diameter of the zones of inhibition, consequently the organism can be described as resistant, intermediate, or sensitive. Tables are used to determine the breakpoint for each drug.

Kirby-Bauer method for determining drug susceptibility 1. 2. 3. 4. 5. Bacteria spread on surface of agar plate 12 disks, each with different antimicrobial drug, placed on agar plate Incubated- drugs diffuse outward and kill susceptible bacteria Zone of inhibition around each disk Compare size of zone to chart
Figure 21. 10


The diameter for size with values listed in a standared chart. The diamete Table (1): Diameter of zone of inhibition (mm) Antibiotics Disk Concentration Resistant Intermediate susceptible Ampicillin* 10 ug 1. 1 or less 12 -13 14 or more Cephalothin 30 ug 14 or less 15 -17 18 or more Chloramphenicol 30 ug 12 or less 13 -17 18 or more Genamicin 10 ug 12 or less 13 -14 15 or more Pencillin** 10 U 20 or less 21 -28 29 or more Polymyxin B 300 U 8 or less 8 -11 12 or more Sulfonamide 300 ug 12 or less 13 -16 17 or more Tetracycline 30 ug 14 or less 15 -18 19 or more * Zone sizes appropriate only when testing Gram-negative enteric organisms ** Zone sizes appropriate only when testing staphylococci.

Other methods to test antimicrobial susceptibility include the E-test also based on antibiotic diffusion. The Epsilometer test (usually abbreviated Etest): is a laboratory test used to determine whether or not a bacterium is susceptible to an antibiotic. The Etest is basically an agar diffusion method. The Etest utilises a rectangular strip that has been impregnated with the drug to be studied. A lawn of bacteria is inoculated onto the surface an agar plate and the Etest strip is laid on top; the drug diffuses out into the agar, producing an exponential gradient of the drug to be tested. There is an exponential scale printed on the strip. After 24 hours of incubation, an elliptical zone of inhibition is produced and the point at which the ellipse meets the strip gives a reading for the (MIC) of the drug.

MIC (Minimum inhibitory concentration): MIC is the lowest concentration of an antimicrobial that will inhibit the visible growth of a microorganism after incubation. - It is important in diagnostic laboratories to confirm resistance of micro organism to an antimicrobial agent. - Also to monitor the activity of new antimicrobial.

Determinatrdion of MIC * Broth Tube Dilution method: - This test is the standard method for determining levels of resistance to an antibiotic. - Serial dilutions of the antibiotic are made in a liquid medium which is inoculated with a standardized number of organisms and incubated for a 24 hours. - The lowest concentration (highest dilution) of antibiotic preventing appearance of turbidity is the (MIC). At this dilution the antibiotic is bacterio static. - The minimal bactericidal concentration (MBC) determined by sub culturing the contents of the tubes onto antibiotic-free solid medium and examining for bacterial growth.

- Slides: 13